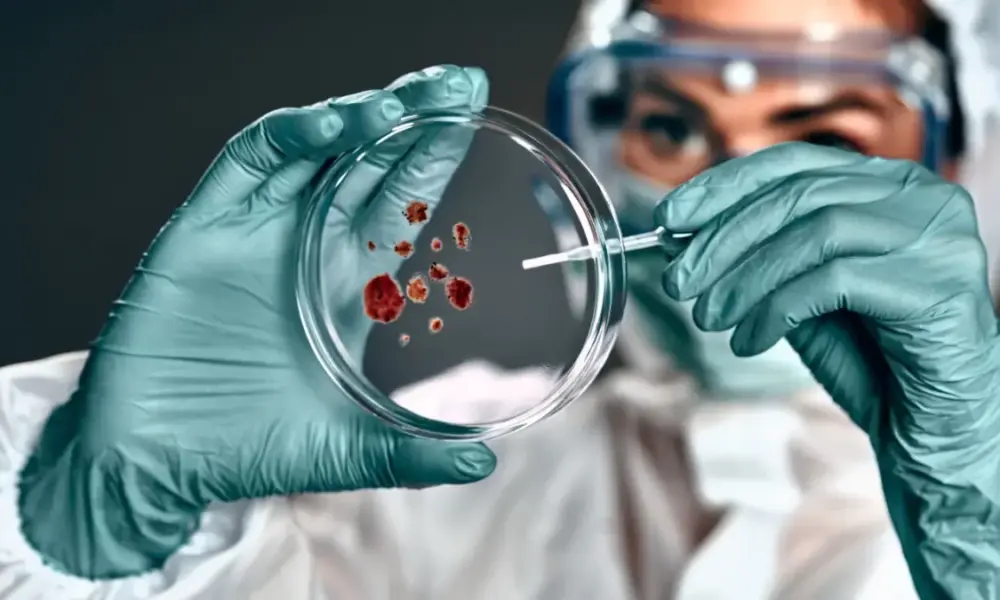

Tantangan Iklim Tropis bagi Peternak Indonesia Indonesia sebagai negara tropis menghadapi tantangan besar dalam budidaya ayam broiler. Suhu tinggi, kelembaban ekstrem, serta perubahan cuaca yang tidak...



Transformasi Industri Perunggasan di Era Otomatisasi Industri perunggasan Indonesia sedang mengalami percepatan transformasi teknologi. Jika sebelumnya digitalisasi berbasis sensor dan aplikasi menjadi sorotan, kini robotik dan...



Pendahuluan: Tantangan Transparansi di Industri Perunggasan Industri perunggasan Indonesia berkembang cepat, namun masih menghadapi tantangan besar dalam transparansi rantai pasok. Konsumen sering tidak mengetahui asal-usul ayam...



Pendahuluan: Era Kecerdasan Buatan di Dunia Peternakan Transformasi teknologi dalam industri perunggasan tidak lagi berhenti pada sensor suhu atau aplikasi pencatatan produksi. Kini, kecerdasan buatan atau...



Pendahuluan: Realitas yang Tidak Bisa Diabaikan Industri perunggasan nasional berkembang pesat dalam dua dekade terakhir. Produksi ayam broiler meningkat signifikan, teknologi kandang semakin modern, dan sistem...



Pendahuluan Industri perunggasan Indonesia telah menjadi tulang punggung penyediaan protein hewani nasional. Ayam broiler adalah komoditas strategis yang menopang ketahanan pangan sekaligus membuka lapangan kerja bagi...



Transformasi dari Individual ke Korporasi Rakyat Selama puluhan tahun, struktur usaha peternakan rakyat di Indonesia berjalan dalam pola individual. Setiap peternak berproduksi sendiri, membeli pakan sendiri,...



Pendahuluan Salah satu persoalan paling berulang dalam industri perunggasan nasional adalah over supply. Ketika produksi ayam melimpah dan daya serap pasar stagnan, harga livebird turun drastis....



Pendahuluan Di tengah dinamika industri perunggasan yang semakin kompetitif, peternak rakyat sering berada dalam posisi rentan. Fluktuasi harga livebird, mahalnya pakan, hingga risiko over supply membuat...

Pendahuluan Industri perunggasan nasional tidak hanya menghadapi tantangan fluktuasi harga dan over supply, tetapi juga ancaman penyakit unggas yang dapat menghancurkan populasi dalam waktu singkat. Dalam...